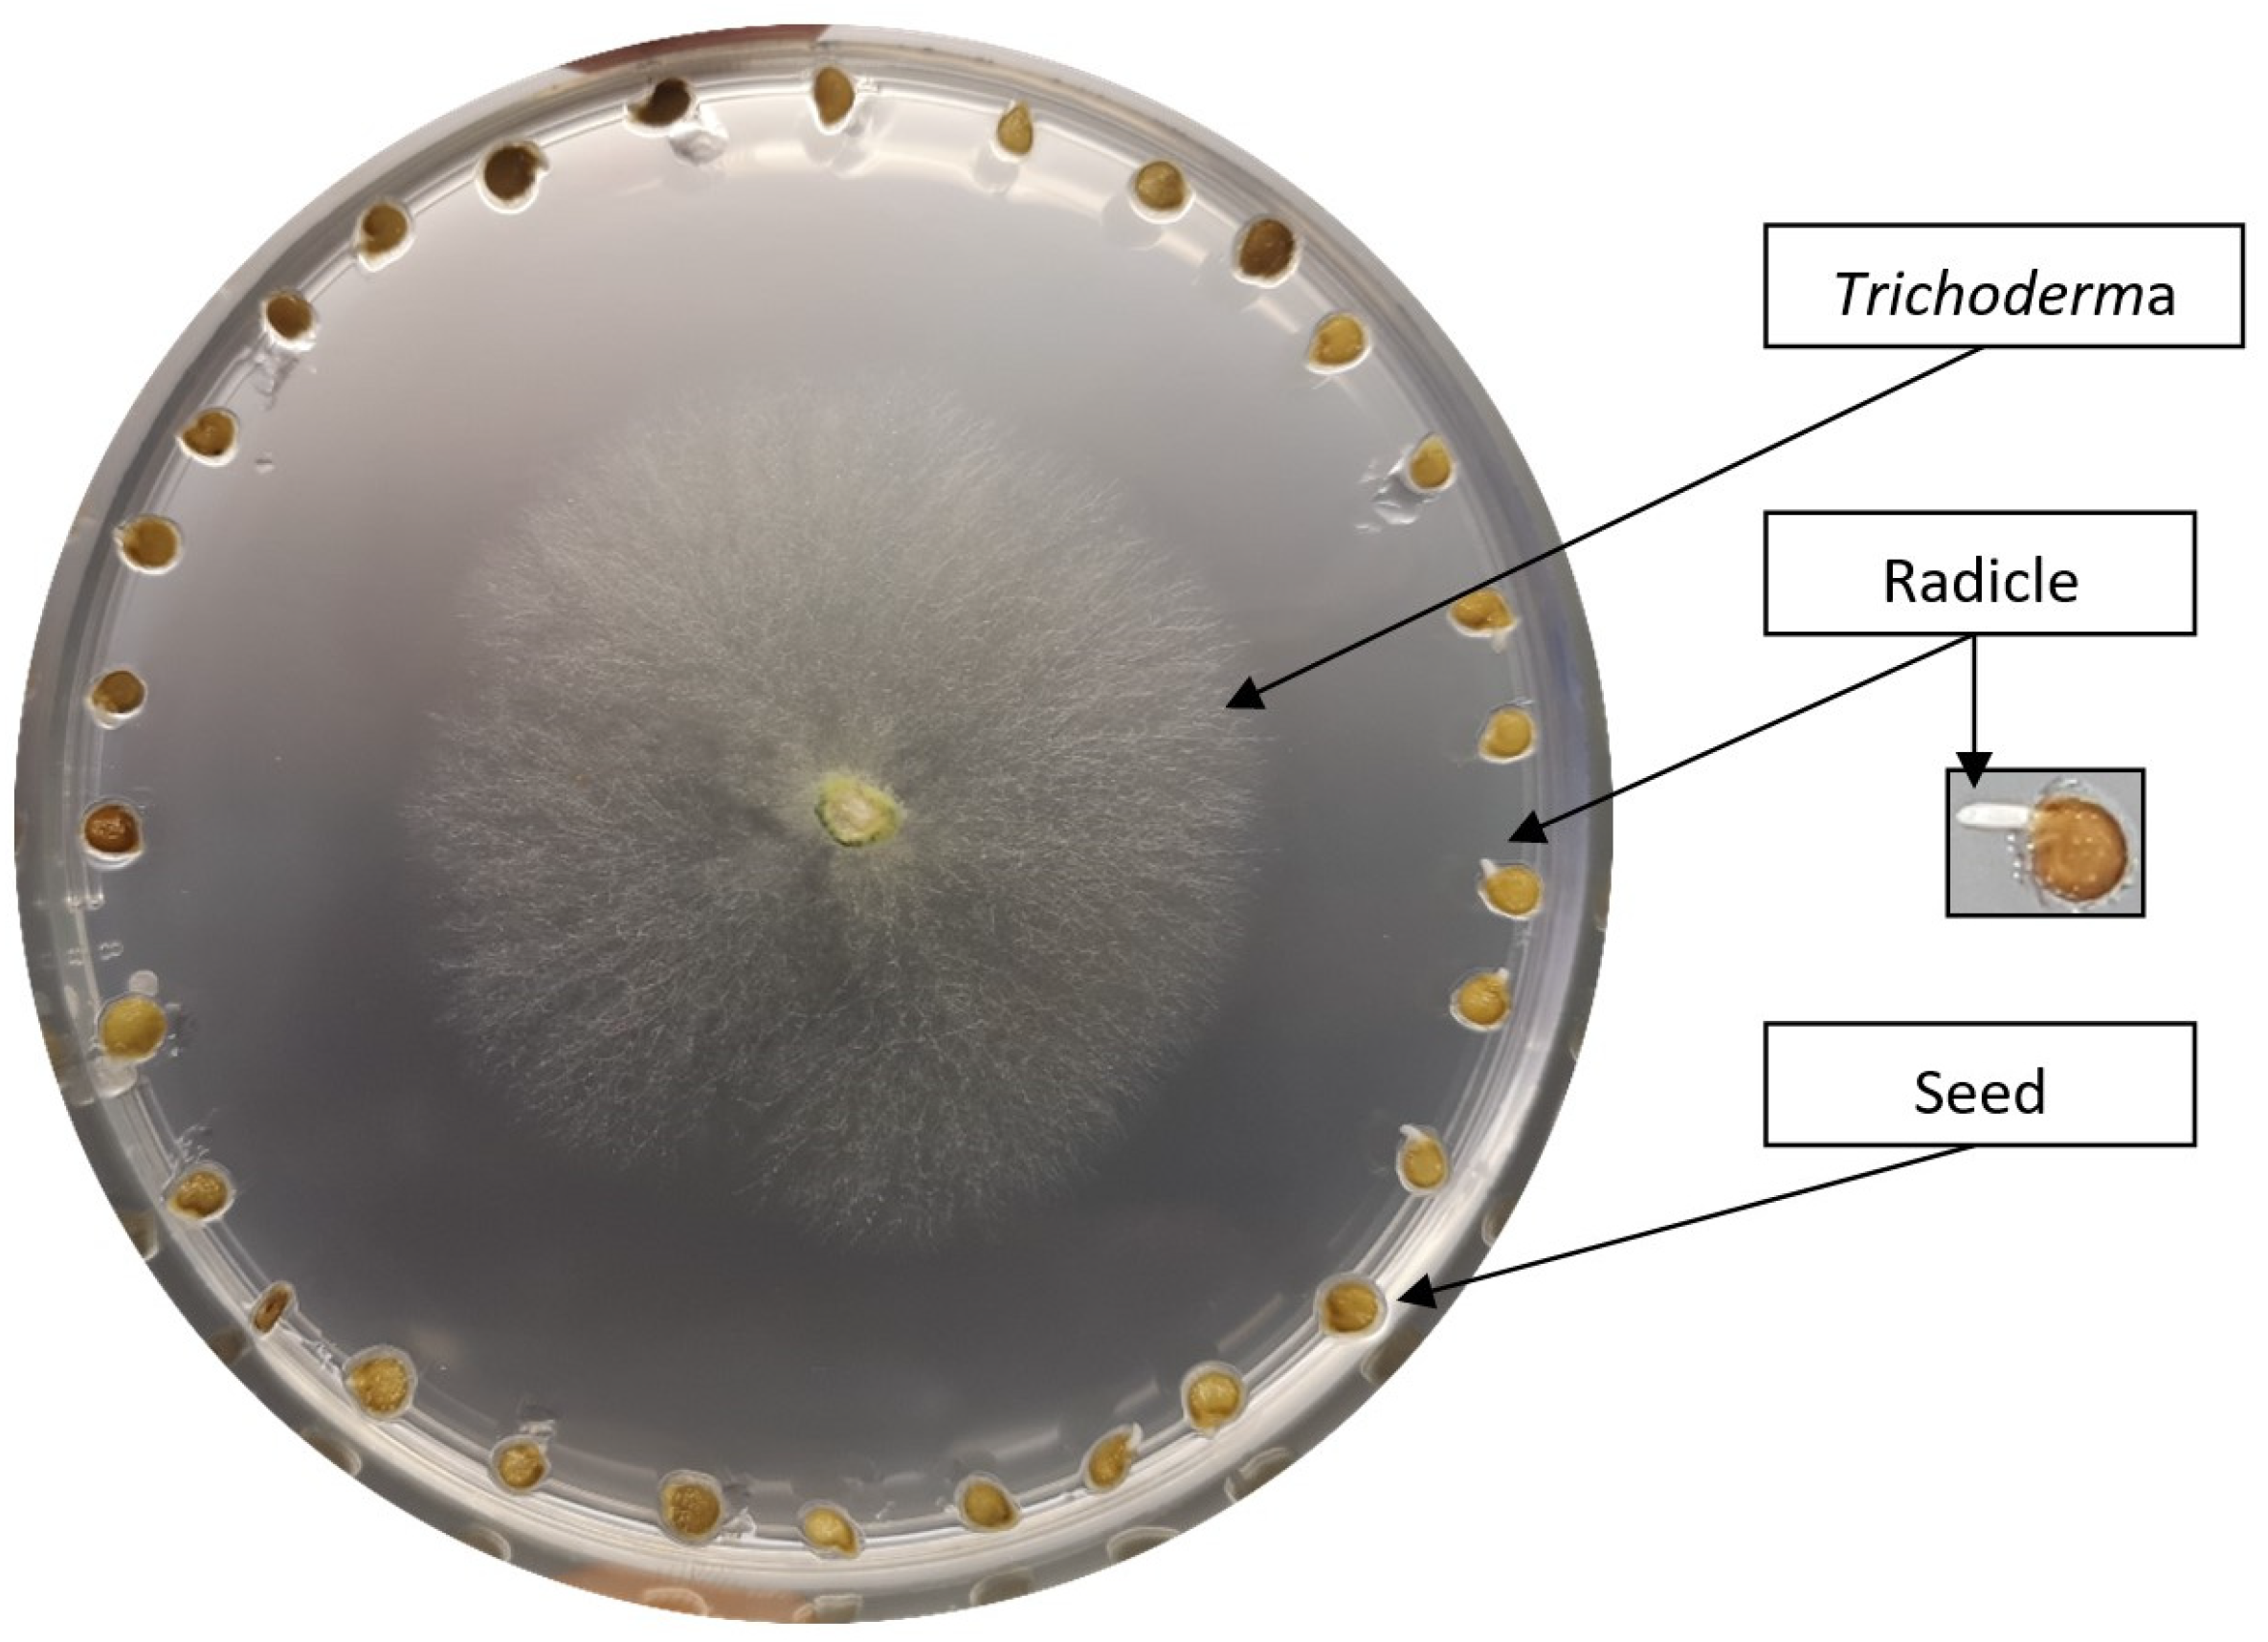
Biology 13 00340 g001

Spectroscopic Investigation of Tomato Seed Germination Stimulated by Trichoderma spp.
Abstract
Simple Summary
Abstract
1. Introduction
2. Materials and Methods
2.1. Fungal Strain and Growth Condition
2.2. Plant Material and Growth Conditions
2.3. Scanning Electron Microscope (SEM) Measurements
2.4. Raman Spectroscopy Measurements
2.5. PCA of Raman Spectra
2.6. Fourier-Transform Infrared Spectroscopy (FTIR) Measurements
2.7. Statistical Analysis
3. Results
3.1. Scanning Electron Micrography (SEM)
3.2. Stimulating In Vitro Tomato Seed Germination with Trichoderma spp.
3.3. Determination of Changes in the Cell Wall Using Raman Spectroscopy
3.4. PCA Analysis of Raman Spectra of Two Tomato Cultivar Radicles in Co-Culture with Either T. harzianum or T. brevicompactum
3.5. FTIR Characterization of Cell Wall Modifications
4. Discussion
| Peak Position (cm−1) | Assignment | References |
|---|---|---|
| 817–832 | C-H out of plane in position 2, 5, and 6 of G units (lignin) | [49] |
| 833 | ring, pectin | [46] |
| 854 | C-H out of plane in position 2, 5, and 6 of G units, aromatic | [49] |
| 921 | C-H out of plane; aromatic | [49] |
| 940–960 | Pectic polysaccharides | [50] |
| 966 | -CH=CH- out-of-plane deformation | [49] |
| 1000–1300 | hemicellulose region | [46,47] |
| 1040 + 1070 | arabinan polysaccharides (hemicellulose) (arabinan, arabinoglucuronoxylan+galactoglucomannan) | [47] |
| 1070 | Xyloglucan | [47,50] |
| 1230–1270 | C–O stretchingvibration in O––C–O, in hemicellulose (xylan), pectin | [47,50,51] |
| 1433–1437 | C-H in phenols | [50] |
| 1520 | Amide II- stretching bands of protein | [40] |
| 1596 | C=O stretching (conjugated aldehydes) in lignin | [49] |
| 1650 | Amide I- stretching bands of protein | [52] |
5. Conclusions
Author Contributions
Funding
Institutional Review Board Statement
Informed Consent Statement
Data Availability Statement
Conflicts of Interest
References
- Pahalvi, H.N.; Rafiya, L.; Rashid, S.; Nisar, B.; Kamili, A.N. Chemical Fertilizers and Their Impact on Soil Health. In Microbiota and Biofertilizers; Dar, G.H., Bhat, R.A., Mehmood, M.A., Hakeem, K.R., Eds.; Springer: Cham, Switzerland, 2021; Volume 2, pp. 1–20. [Google Scholar]
- Usigbe, M.J.; Asem-Hiablie, S.; Uyeh, D.D.; Iyiola, O.; Park, T.; Mallipeddi, R. Enhancing resilience in agricultural production systems with AI-based technologies. Environ. Dev. Sustain. 2023, 2, 1–29. [Google Scholar] [CrossRef]
- Andrade-Hoyos, P.; Silva-Rojas, H.V.; Romero-Arenas, O. Endophytic Trichoderma species isolated from Persea americana and Cinnamomum verum roots reduce symptoms caused by Phytophthora cinnamomi in avocado. Plants 2020, 9, 1220. [Google Scholar] [CrossRef]
- Silletti, S.; Di Stasio, E.; Van Oosten, M.J.; Ventorino, V.; Pepe, O.; Napolitano, M.; Marra, R.; Woo, S.L.; Cirillo, V.; Maggio, A. Biostimulant activity of Azotobacter chroococcum and Trichoderma harzianum in Durum wheat under water and nitrogen deficiency. Agronomy 2021, 11, 380. [Google Scholar] [CrossRef]
- Quinet, M.; Angosto, T.; Yuste-Lisbona, F.J.; Blanchard-Gros, R.; Bigot, S.; Martinez, J.P.; Lutts, S. Tomato fruit development and metabolism. Front. Plant Sci. 2019, 10, 1554. [Google Scholar] [CrossRef]
- Farooq, M.S.M.A.; Basra, S.M.A.; Saleem, B.A.; Nafees, M.; Chishti, S.A. Enhancement of tomato seed germination and seedling vigor by osmopriming. Pak. J. Agric. Sci. 2005, 42, 3–4. [Google Scholar]
- Sharma, S.; Kour, D.; Rana, K.L.; Dhiman, A.; Thakur, S.; Thakur, P.; Thakur, S.; Thakur, N.; Sudheer, S.; Yadav, N. Trichoderma: Biodiversity, ecological significances, and industrial applications. In Recent Advancement in White Biotechnology through Fungi; Springer: Berlin/Heidelberg, Germany, 2019; pp. 85–120. [Google Scholar]
- Ahluwalia, V.; Kumar, J.; Rana, V.S.; Sati, O.P.; Walia, S. Comparative evaluation of two Trichoderma harzianum strains for major secondary metabolite production and antifungal activity. Nat. Prod. Res. 2015, 29, 914–920. [Google Scholar] [CrossRef]
- Karuppiah, V.; Li, T.; Vallikkannu, M.; Chen, J. Co-cultivation of Trichoderma asperellum GDFS1009 and Bacillus amyloliquefaciens 1841 causes differential gene expression and improvement in the wheat growth and biocontrol activity. Front. Microbiol. 2019, 10, 1068. [Google Scholar] [CrossRef]
- Juliatti, F.C.; Rezende, A.A.; Juliatti, B.C.M.; Morais, T.P. Trichoderma—The Most Widely Used Fungicide. IntechOpen: London, UK, 2019. [Google Scholar]
- Racić, G.; Vukelić, I.; Prokić, L.; Ćurčić, N.; Zorić, M.; Jovanović, L.; Panković, D. The influence of Trichoderma brevicompactum treatment and drought on physiological parameters, abscisic acid content and signalling pathway marker gene expression in leaves and roots of tomato. Ann. Appl. Biol. 2018, 173, 213–221. [Google Scholar] [CrossRef]
- Cornejo-Ríos, K.; Osorno-Suárez, M.d.P.; Hernández-León, S.; Reyes-Santamaría, M.I.; Juárez-Díaz, J.A.; Pérez-España, V.H.; Peláez-Acero, A.; Madariaga-Navarrete, A.; Saucedo-García, M. Impact of Trichoderma asperellum on chilling and drought stress in tomato (Solanum lycopersicum). Horticulturae 2021, 7, 385. [Google Scholar] [CrossRef]
- Bashyal, B.M.; Parmar, P.; Zaidi, N.W.; Aggarwal, R. Molecular programming of drought-challenged Trichoderma harzianum-bioprimed rice (Oryza sativa L.). Front. Microbiol. 2021, 12, 655165. [Google Scholar] [CrossRef]
- Sánchez-Montesinos, B.; Diánez, F.; Moreno-Gavira, A.; Gea, F.J.; Santos, M. Plant growth promotion and biocontrol of Pythium ultimum by saline tolerant Trichoderma isolates under salinity stress. Int. J. Environ. Res. Public Health 2019, 16, 2053. [Google Scholar] [CrossRef]
- Brotman, Y.; Landau, U.; Cuadros-Inostroza, Á.; Takayuki, T.; Fernie, A.R.; Chet, I.; Viterbo, A.; Willmitzer, L. Trichoderma-plant root colonization: Escaping early plant defense responses and activation of the antioxidant machinery for saline stress tolerance. PLoS Pathog. 2013, 9, e1003221. [Google Scholar] [CrossRef]
- Maurya, S.; Rashk-E-Eram; Naik, S.K.; Choudhary, J.S.; Kumar, S. Heavy metals scavenging potential of Trichoderma asperellum and Hypocrea nigricans isolated from acid soil of Jharkhand. Indian J. Microbiol. 2019, 59, 27–38. [Google Scholar] [CrossRef]
- Sun, H.; Wu, L.; Hao, Y.; Liu, C.; Pan, L.; Zhu, Z. Tolerance mechanism of Trichoderma asperellum to Pb2+: Response changes of related active ingredients under Pb2+ stress. RSC Adv. 2020, 10, 5202–5211. [Google Scholar] [CrossRef]
- Ghorbanpour, A.; Salimi, A.; Ghanbary, M.A.T.; Pirdashti, H.; Dehestani, A. The effect of Trichoderma harzianum in mitigating low temperature stress in tomato (Solanum lycopersicum L.) plants. Sci. Hortic. 2018, 230, 134–141. [Google Scholar] [CrossRef]
- Contreras-Cornejo, H.A.; Macías-Rodríguez, L.; del-Val, E.; Larsen, J. Ecological functions of Trichoderma spp. and their secondary metabolites in the rhizosphere: Interactions with plants. FEMS Microbiol. Ecol. 2016, 92, 036. [Google Scholar] [CrossRef]
- Kubicek, C.P.; Steindorff, A.S.; Chenthamara, K.; Manganiello, G.; Henrissat, B.; Zhang, J. Evolution and comparative genomics of the most common Trichoderma species. BMC Genom. 2019, 20, 485. [Google Scholar] [CrossRef]
- Mastouri, F.; Björkman, T.; Harman, G.E. Seed treatment with Trichoderma harzianum alleviates biotic, abiotic, and physiological stresses in germinating seeds and seedlings. Phytopathology 2010, 100, 1213–1221. [Google Scholar] [CrossRef]
- Rajjou, L.; Duval, M.; Gallardo, K.; Catusse, J.; Bally, J.; Job, C.; Job, D. Seed germination and vigor. Annu. Rev. Plant Biol. 2012, 63, 507–533. [Google Scholar] [CrossRef]
- Li, W.; Niu, Y.; Zheng, Y.; Wang, Z. Advances in the understanding of reactive oxygen species-dependent regulation on seed dormancy, germination, and deterioration in crops. Front. Plant Sci. 2022, 13, 826809. [Google Scholar] [CrossRef]
- You, J.; Zhang, J.; Wu, M.; Yang, L.; Chen, W.; Li, G. Multiple criteria-based screening of Trichoderma isolates for biological control of Botrytis cinerea on tomato. Biol. Control 2016, 101, 31–38. [Google Scholar] [CrossRef]
- Jogaiah, S.; Abdelrahman, M.; Tran, L.S.P.; Ito, S.I. Different mechanisms of Trichoderma virens—Mediated resistance in tomato against Fusarium wilt involve the jasmonic and salicylic acid pathways. Mol. Plant Pathol. 2018, 19, 870–882. [Google Scholar] [CrossRef]
- González-Pérez, E.; Ortega-Amaro, M.A.; Salazar-Badillo, F.B.; Bautista, E.; Douterlungne, D.; Jiménez-Bremont, J.F. The Arabidopsis-Trichoderma interaction reveals that the fungal growth medium is an important factor in plant growth induction. Sci. Rep. 2018, 8, 16427. [Google Scholar] [CrossRef]
- Vukelić, I.D.; Prokić, L.T.; Racić, G.M.; Pešić, M.B.; Bojović, M.M.; Sierka, E.M.; Panković, D.M. Effects of Trichoderma harzianum on photosynthetic characteristics and fruit quality of tomato plants. Int. J. Mol. Sci. 2021, 22, 6961. [Google Scholar] [CrossRef]
- Tucci, M.; Ruocco, M.; De Masi, L.; De Palma, M.; Lorito, M. The beneficial effect of Trichoderma spp. on tomato is modulated by the plant genotype. Mol. Plant Pathol. 2011, 12, 341–354. [Google Scholar] [CrossRef]
- Racić, G.; Körmöczi, P.; Kredics, L.; Raičević, V.; Mutavdžić, B.; Vrvić, M.M.; Panković, D. Effect of the edaphic factors and metal content in soil on the diversity of Trichoderma spp. Environ. Sci. Pollut. Res. 2017, 24, 3375–3386. [Google Scholar] [CrossRef]
- Racić, G. Variability of Indigenous Trichoderma spp. in Different Soil Types and Their Ecological and Biochemical Characterization. Ph.D. Thesis, University of Belgrade, Belgrade, Sebia, 2017. [Google Scholar]
- Murashige, T.; Skoog, F. A revised medium for rapid growth and bio assays with tobacco tissue cultures. Physiol. Plant. 1962, 15, 473–497. [Google Scholar] [CrossRef]
- Institute for Vegetable Crops, Smederevska Palanka. Available online: https://institut-palanka.rs/ (accessed on 17 January 2018).
- Đorđević, M.; Vatchev, T.; Girek, Z.; Šević, M.; Zečević, B.; Zdravković, J.; Ivanović, M. Reaction of different tomato cultivars toward race 1 of Fusarium oxysporum f. sp. Lycopersici. Genetika 2012, 44, 109–118. [Google Scholar]
- Clearya, M.R.; Danielb, G.; Stenlid, J. Light and scanning electron microscopy studies of the early infection stages of Hymenoscyphus pseudoalbiduson Fraxinus excelsior. Molecules 2022, 27, 4616. [Google Scholar]
- Menges, F. Spectragryph—Optical Spectroscopy Software, Version 1.2.8; Spectragryph: Oberstdorf, Germany, 2018. Available online: http://www.effemm2.de/spectragryph/ (accessed on 12 March 2019).
- Hammer, Ø.; Harper, D.A.T.; Ryan, P.D. PAST: Paleontological statistics software package for education and data analysis. Palaeont. Electr. 2001, 4, 9. [Google Scholar]
- Global Analytical and Measuring Instruments. Available online: https://www.shimadzu.com/an/service-support/technical-support/analysisbasics/ftirtalk/talk8.html (accessed on 17 January 2018).
- Konappa, N.; Krishnamurthy, S.; Arakere, U.C.; Chowdappa, S.; Ramachandrappa, N.S. Efficacy of indigenous plant growth-promoting rhizobacteria and Trichoderma strains in eliciting resistance against bacterial wilt in a tomato. Egypt. J. Biol. Pest Control 2020, 30, 30. [Google Scholar] [CrossRef]
- Anjum, Z.A.; Hayat, S.; Ghazanfar, M.U.; Ahmad, S.; Adnan, M.; Hussian, I. Does seed priming with Trichoderma isolates have any impact on germination and seedling vigor of wheat. Int. J. Bot. Stud. 2020, 5, 65–68. [Google Scholar]
- Gierlinger, N. Revealing changes in molecular composition of plant cell walls on the micron-level by Raman mapping and vertex component analysis (VCA). Front. Plant Sci. 2014, 5, 306. [Google Scholar] [CrossRef]
- Keegstra, K. Plant cell walls. Plant Physiol. 2010, 154, 483–486. [Google Scholar] [CrossRef]
- Carpita, N.C.; Gibeaut, D.M. Structural models of primary cell walls in flowering plants: Consistency of molecular structure with the physical properties of the walls during growth. Plant J. 1993, 3, 1–30. [Google Scholar] [CrossRef]
- Di Marzo, M.; Babolin, N.; Viana, V.E.; de Oliveira, A.C.; Gugi, B.; Caporali, E.; Herrera-Ubaldo, H.; Martínez-Estrada, E.; Driouich, A.; de Folter, S.; et al. The Genetic Control of SEEDSTICK and LEUNIG-HOMOLOG in Seed and Fruit Development: New Insights into Cell Wall Control. Plants 2022, 11, 3146. [Google Scholar] [CrossRef]
- Broxterman, S.E.; Schols, H.A. Characterisation of pectin-xylan complexes in tomato primary plant cell walls. Carbohydr. Polym. 2018, 197, 269–276. [Google Scholar] [CrossRef]
- Cosgrove, D.J. Growth of the plant cell wall. Nat. Rev. Mol. Cell Biol. 2005, 6, 850–861. [Google Scholar] [CrossRef]
- Kacuráková, M.; Smith, A.C.; Gidley, M.J.; Wilson, R.H. Molecular interactions in bacterial cellulose composites studied by 1D FT-IR and dynamic 2D FT-IR spectroscopy. Carbohydr Res. 2002, 337, 1145–1153. [Google Scholar] [CrossRef]
- Kačuráková, M.; Capek, P.; Sasinková, V.; Wellner, N.; Ebringerová, A. FT-IR study of plant cell wall model compounds: Pectic polysaccharides and hemicelluloses. Carbohydr. Polym. 2000, 43, 195–203. [Google Scholar] [CrossRef]
- Schulz, H.; Baranska, M. Identification and Quantification of Valuable Plant Substances by IR and Raman Spectroscopy. Vib. Spectrosc. 2007, 43, 13–25. [Google Scholar] [CrossRef]
- Faix, O. Classification of Lignins from Different Botanical Origins by FT-IR Spectroscopy. Holzforschung 1991, 45, 21–28. [Google Scholar] [CrossRef]
- Alonso-Simón, A.; García-Angulo, P.; Mélida, H.; Encina, A.; Álvarez, J.M.; Acebes, J.L. The use of FTIR spectroscopy to monitor modifications in plant cell wall architecture caused by cellulose biosynthesis inhibitors. Plant Signal Behav. 2011, 6, 1104–1110. [Google Scholar] [CrossRef]
- Chowdappa, P.; Kumar, S.M.; Lakshmi, M.J.; Upreti, K.K. Growth stimulation and induction of systemic resistance in tomato against early and late blight by Bacillus subtilis OTPB1 or Trichoderma harzianum OTPB3. Biol. Control 2013, 65, 109–117. [Google Scholar] [CrossRef]
- McCann, M.C.; Hammouri, M.; Wilson, R.; Belton, P.; Roberts, K. Fourier transform infrared microspectroscopy is a new way to look at plant cell walls. Plant Physiol. 1992, 100, 1940–1947. [Google Scholar] [CrossRef]
- Basińska-Barczak, A.; Błaszczyk, L.; Szentner, K. Plant cell wall changes in common wheat roots as a result of their interaction with beneficial fungi of Trichoderma. Cells 2020, 9, 2319. [Google Scholar] [CrossRef]
- Pehlivan, N.; Yesilyurt, A.M.; Durmus, N.; Karaoglu, S.A. Trichoderma lixii ID11D seed biopriming mitigates dose dependent salt toxicity in maize. Acta Physiol. Plant. 2017, 39, 79. [Google Scholar] [CrossRef]
- Alhomodi, A.F.; Zavadil, A.; Berhow, M.; Gibbons, W.R.; Karki, B. Composition of canola seed sprouts fermented by Aureobasidium pullulans, Neurospora crassa, and Trichoderma reesei under submerged-state fermentation. Food Bioprod. Process. 2021, 126, 256–264. [Google Scholar] [CrossRef]
- Zhang, B.; Gao, Y.; Zhang, L.; Zhou, Y. The plant cell wall: Biosynthesis, construction, and functions. J. Integr. Plant Biol. 2021, 63, 251–272. [Google Scholar] [CrossRef]
- Rangel, P.N.; Tovborg, M.; Soleimani, F.A.; Della, P.E.A. Multicomponent carbohydrase system from Trichoderma reesei: A toolbox to address complexity of cell walls of plant substrates in animal feed. PLoS ONE 2021, 16, e0251556. [Google Scholar]
- Danilovic, G.; Radic, D.; Raicevic, V.; Jovanovic, L.; Kredics, L.; Pankovic, D. Extracellular enzyme activity of Trichoderma strains isolated from different soil types. In Proceedings of the 2nd International Symposium for Agriculture and Food, Ohrid, Republic of Macedonia, 7–9 October 2015; pp. 323–327. [Google Scholar]
- dos Prazeres, J.N.; Ferreira, C.V.; Aoyama, H. Acid phosphatase activities during the germination of Glycine max seeds. Plant Physiol. Biochem. 2004, 42, 15–20. [Google Scholar] [CrossRef]
- Thomas, T.L. Gene expression during plant embryogenesis and germination: An overview. Plant Cell 1993, 5, 1401. [Google Scholar]
- Yi, C.K. Increase in β-N-acetylglucosaminidase activity during germination of cotton seeds. Plant Physiol. 1981, 67, 68–73. [Google Scholar] [CrossRef]
- Berger, S.; Menudier, A.; Julien, R.; Karamanos, Y. Endo-N-acetyl-β-D-glucosaminidase and peptide-N4-(N-acetyl-glucosaminyl) asparagine amidase activities during germination of Raphanus sativus. Phytochemistry 1995, 39, 481–487. [Google Scholar] [CrossRef]
- Cao, S.; Liu, Y.; Shi, L.; Zhu, W.; Wang, H. N-Acetylglucosamine as a platform chemical produced from renewable resources: Opportunity, challenge, and future prospects. Green Chem. 2022, 24, 493–509. [Google Scholar] [CrossRef]

| Genus | Species | Code | No. of Isolates in the SZMC Collection | Accession Number |
|---|---|---|---|---|
| Trichoderma | harzianum | T4 | 22660 | KP316448.1 |
| Trichoderma | brevicompactum | T9 | 22661 | KP316440.1 |
| Trichoderma | virens | T7 | 22659 | KP316449.1 |
| Trichoderma | longibrachiatum | T11 | 22664 | KP316444.1 |
| Trichoderma | citrinoviride | T13 | 22668 | KP316445.1 |
Disclaimer/Publisher’s Note: The statements, opinions and data contained in all publications are solely those of the individual author(s) and contributor(s) and not of MDPI and/or the editor(s). MDPI and/or the editor(s) disclaim responsibility for any injury to people or property resulting from any ideas, methods, instructions or products referred to in the content. |
© 2024 by the authors. Licensee MDPI, Basel, Switzerland. This article is an open access article distributed under the terms and conditions of the Creative Commons Attribution (CC BY) license (https://creativecommons.org/licenses/by/4.0/).
Share and Cite
Vukelić, I.; Radić, D.; Pećinar, I.; Lević, S.; Djikanović, D.; Radotić, K.; Panković, D. Spectroscopic Investigation of Tomato Seed Germination Stimulated by Trichoderma spp. Biology 2024, 13, 340. https://doi.org/10.3390/biology13050340
Vukelić I, Radić D, Pećinar I, Lević S, Djikanović D, Radotić K, Panković D. Spectroscopic Investigation of Tomato Seed Germination Stimulated by Trichoderma spp. Biology. 2024; 13(5):340. https://doi.org/10.3390/biology13050340
Chicago/Turabian StyleVukelić, Igor, Danka Radić, Ilinka Pećinar, Steva Lević, Daniela Djikanović, Ksenija Radotić, and Dejana Panković. 2024. "Spectroscopic Investigation of Tomato Seed Germination Stimulated by Trichoderma spp." Biology 13, no. 5: 340. https://doi.org/10.3390/biology13050340
APA StyleVukelić, I., Radić, D., Pećinar, I., Lević, S., Djikanović, D., Radotić, K., & Panković, D. (2024). Spectroscopic Investigation of Tomato Seed Germination Stimulated by Trichoderma spp. Biology, 13(5), 340. https://doi.org/10.3390/biology13050340

